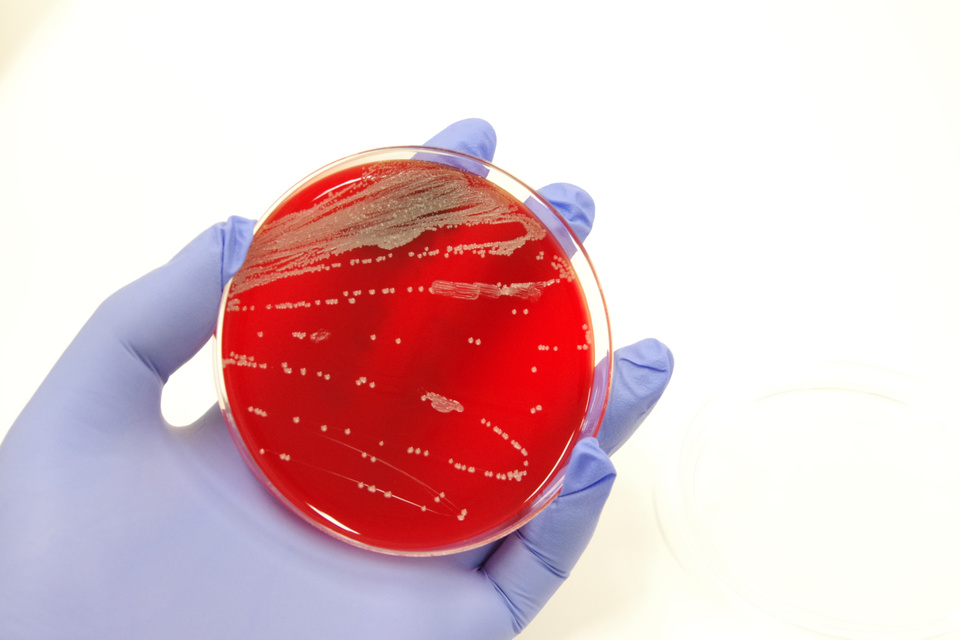

カビ毒
かび毒とは、植物病原菌であるかびや貯蔵穀物などを汚染するかびが産生する化学物質で、人や家畜の健康に悪影響を及ぼすものをいいます。OMICでは、長年の実績をもとに、カビ毒をはじめとする多様な有害物質の分析試験に対応しております。
1. 主な分析項目
Aflatoxins (B1, B2, G1, G2)
Citrinin
Cytochalasin E
Fumonisin B1+B2+B3
HT2 Toxin
Nivalenol
Ochratoxin A
Patulin
Sterigmatocistin
T2 Toxin
Vomitoxin (3-ADON)
Vomitoxin (15-ADON)
Vomitoxin/Deoxynivalenol (DON)
Zearalenone
2. 分析料金等
分析の可否や料金は、分析項目や対象作物によって異なります。
また、分析日数・必要サンプル量・送付方法・分析所要日数等も、条件により異なりますので、詳細については、お気軽にお問い合わせ下さい。
お見積り・依頼の流れ